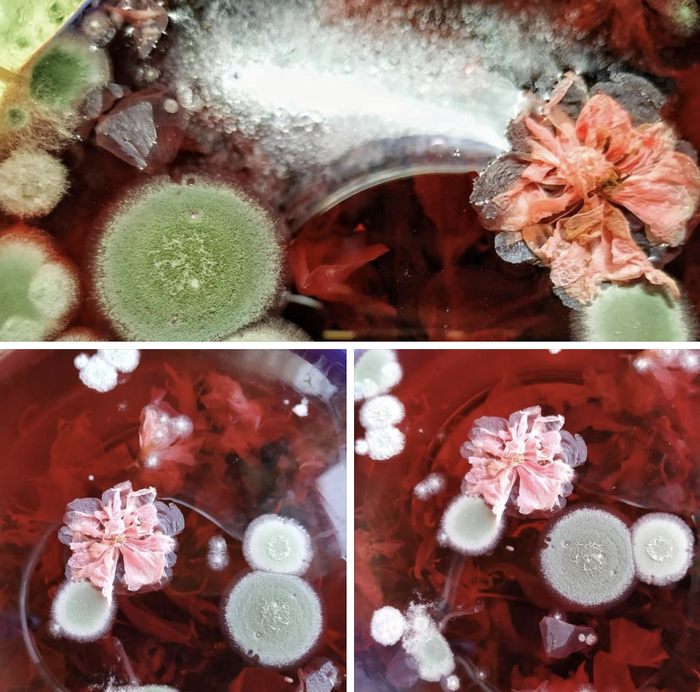
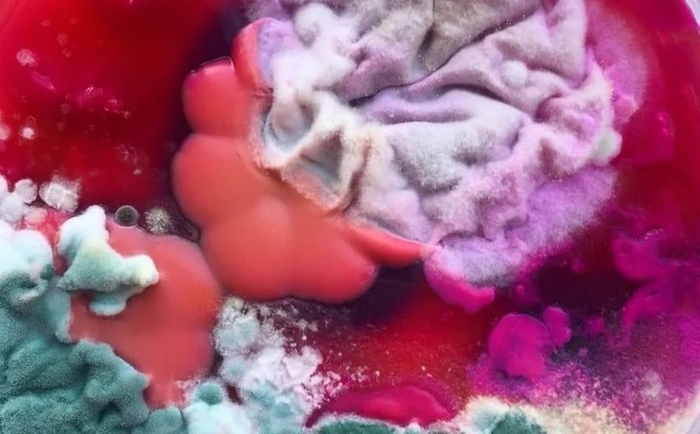

cryzovnic
Рождественский дизайн Дали для «Vogue» 1946 года
Также Сальвадор Дали написал серию из девятнадцати рождественских открыток в период с 1958-ой по 1976-ой год. Сюрреализм и рождественские открытки - довольно странное сочетание, что, как мне кажется, и доказал художник.
Несмотря на известное имя автора, в Америке к открыткам отнеслись очень холодно, назвав их «излишне авангардными». А как вы считаете, отражают ли сюрреалистические ёлочки дух Рождества? На мой взгляд, дух Рождества последних лет они отражают вполне. Особенно последняя открытка меня впечатлила. Чёрные человечки с поднятыми руками явно кричат «спасити-памагити», да и ёлочка довольно заманчиво горит:)
«Я вырастил плесень» - это
название одной из групп, в которых я состою. И там ну очень красиво! Природа, подчас, принимает удивительные формы. Вот, принесла сюда, полюбуйтесь! Ну разве это не прекрасно?
Это плесень на маринаде с помидорками.
А это - сметанка двухнедельной давности.
Тут не знаю, что, но такой милый пушистик!
Это что-то из фильма ужасов: макароны жалобно тянут макоронинки наружу.
Чай каркаде. Восхитителен, нет?
Ну, это, полагаю, все узнали:)))
Тыквенный суп-пюре.
Просто что-то красивое:)
Цветочный чай.
По-моему, это прекрасно!
Про гниду Хосе
У Пирожка (мой бойфренд) на работе завелась гнида. Но не какая-нибудь там просто гнида, нет, а мексиканская. У гниды длинное невыговариваемое имя, в котором есть отсылка и к Иисусу, и к деве Марии, и, кажется, ко всем святым угодникам. Навроде Хосе Хесус Мария Мартинес Гарсия а ля Тринидад деи Вега.
Джон Ын, Джон Ун и Джун Гын, аспиранты в Пирожковой лабе, сразу же сказали, что выговорить это не смогут и гнида милостиво согласилась именоваться просто «Хосе».
Каждое утро, приходя в лабу - хотя какое утро, Хосе заявлялся часам к одиннадцати примерно, - он ставил телефон на зарядку и включал звук. Хосе - гнида социально активная, поэтому пипиканье мессенджеров и уведомлений раздавалось каждую минуту, что невероятно выбешивало работающих рядом коллег. Джон Ын не сказал ни слова, а просто каждый раз стал плевать в кофе гниды, таким образом вымещая своё недовольство. Джон Ун подал заявление на перевод в другую лабу. И только Джон Гын попытался сделать замечание оборзевшему мексиканцу, но, получив в ответ грозный взгляд из-под насупленных бровей, сопровождаемый вопросом: «Чё, самый умный штоле?», тут же отвалился и отправился в магазин покупать беруши. Так продолжалось две недели, а потом с каникул вернулся Пирожок.
Впервые услышав звук уведомления, Пирожок нервно дёрнулся - ещё несколько лет назад, став тимлидом, он установил правило, гласившее, что в лабе всегда должна быть гробовая тишина. Звук повторился снова, а потом опять. Пирожок удивлённо воззрился на новенького.
- Ты, наверное, не знаешь, что в лаборатории присутствуют определённые правила? - обратился Пирожок к новоиспечённому аспиранту. - Телефоны в лабе выключаются или ставятся на бесшумный режим.
- Ммм… - Хосе пристально разглядывал оппонента и, сделав вывод, что тот не представляет особой опасности, заявил: - А тебе что за печаль?
- Я, вообще-то, работаю! - возмутился Пирожок и, подумав, добавил - В отличие от тебя!
- Я тоже работаю, так что отвали!
У Пирожочка глаза округлились, а челюсть пошла на сближение с полом: так с ним никто ещё не разговаривал.
- Значит, так! - Пирожок подобрал упавшую на пол челюсть. - Либо ты выключаешь телефон, либо выметайся отсюда!
- Шта??? - мексиканец сделал шаг вперёд и произнёс классическое - А ты кто такой? Не нравится - вали в другую лабу, как корейские з@дроты свалили! Телефон мне нужен для работы, а будешь меня доставать, я пожалуюсь дину (dean, декан факультета), и у тебя будут проблемы!
- Ой ли? - Пирожок хитро прищурился. - Так может, прямо сейчас и пожалуешься?
- А что? - злосчастная карма неотвратимо толкала терпилу в пропасть. - Сейчас и пожалуюсь!
И самоуверенный мексиканец бодро отправился в кабинет декана факультета. Спустя пять минут туда подошёл и Пирожок.
- Доброе утро, профессор! - Пирожок протянул руку.
- Здравствуйте, доктор ***, Вы очень кстати! Молодой человек - дин указал рукой на мексиканца, - жалуется, что Вы не разрешаете ему пользоваться телефоном в лаборатории.
- Так и есть, профессор! - согласно кивнул головой Пирожок.
Дин хитро посмотрел на Пирожка и они оба рассмеялись. Хосе понял, что что-то пошло не по плану.
- Нужно извинить его, - дин кивнул в сторону опростоволосившегося аспиранта. - Молод, глуп. Только две недели, как в университете.
- Да, дин, конечно. Но как быть с телефоном?
- Каждый раз, когда Вы приходите в лабораторию университета, Вы должны будете оставлять телефон на стойке охраны. - обратился дин к студенту.
- Но как же… - попытался возразить тот. - Другие же пользуются.
- Пользоваться телефоном в лаборатории могут только старшие сотрудники. Такие, как Ваш тимлид.
- Тимлид?... - ахнул мексиканец и опустил глаза, поняв, как обложался. - Простите, сэр, я не знал.
- Ну, теперь Вы знаете. Я оставлю сообщение охране, чтобы каждый раз проверяла Вас на наличие телефона и с телефоном в лабораторию Вас не впускала. Можете быть свободны. - дин указал студенту на дверь и тот покорно проследовал на выход.
- Может быть, по чашечке кофе? - обратился дин к Пирожку. - С коньячком, а?
И Пирожок задержался ненадолго у дина, чтобы испить кофею и обсудить занятный случай, участником которого он невольно стал. По возвращении в лабораторию Пирожок обнаружил, что мексиканец исчез. Пропали все его вещи, книги и телефон. Как оказалось позже, он добровольно переместился в дальний закуток лабы, рядом с туалетом, которым брезговали все. Очевидно, сделано это было, чтобы поменьше встречаться с тимлидом. Но судьба такая шутница! И обожает сталкивать лбами людей.
В саду универа поспел инжир. А я инжир обожаю и давно уже говорила Пирожку: пойдём, обтрясём деревья. Но он, как всегда, отговаривался: ой, я не такая, я жду трамвая. Но инжир парень тоже нежно любит и потому, поддавшись на мои уговоры, поздно ночью, захватив пару больших чёрных пакетов, мы отправились за инжиром.
Как оказалось, всё, что висело внизу, люди уже оборвали, оставив инжир только на самой верхушке дерева.
- Тряси! - велела я Пирожку.
- Стрёмно как-то!
- Тряси, тебе говорят!
Пока Пирожок мялся и терзался сомнениями, я бысто вскарабкалась вверх по стволу и слегка тряхнула дерево. Инжирины посыпались вниз.
- Собирай давай! - прокричала я сверху и тряханула дерево посильней. Пирожок спешно принялся подбирать упавшие инжирины и складывать их в пакет.
Долго ли коротко ли, но пока мы были заняты сбором урожая, на дорожке, ведущей в сад, показались ещё три фигуры с двумя обширными сумками в руках. Очевидно, ребята тоже решили набрать инжира. Заметив меня на дереве, они остановились.
- Эй, ты! - Проорал один из них. - Ты чой-то там делаешь?
Пирожок замер и спрятался в кусты.
- А тебе что за дело? Проходя мимо - проходите мимо. - крикнула я пришедшим.
- Ты, никак, инжир обтрясаешь, а? А ты знаешь, что этот сад - собственность факультета и мы можем пожаловаться на тебя в деканат!
- А вы сюда, значит, прогуляться пришли? - взоржала я. - Мама не учила тебя, бомбино, что врать плохо? Сумки-то зачем притащили? Не для того ли, чтобы инжир туда складывать?
- Ну, мы имеем на это полное право! Я - тимлид факультетской лабы!
Я заржала. Пирожок в кустах прифигел от такой наглости.
- Таких тимлядей - я потихоньку стала спускаться с дерева, - за тимлидник да в музей! 🤣🤣🤣
Я спустилась с дерева и вышла на свет.
- Ой, так ты старая! - пискнул один из потенциальных спиzживателей инжира. Присмотревшись повнимательнее, я поняла, что все они были латинос, лет 20-25.
- Hola, cabrones! (привет, придурки!) - обратилась я к ним на испанском. - Там дальше есть ещё пара инжирных деревьев, идите туда.
- Ах ты, сучка! - тут же отреагировал на «cabrones» один из компашки. Но продолжить не успел. Кусты раздвинулись и доктор IT-инженерии явил себя офигевшим студентам.
- Здравствуй, Хосе! - отряхивая мелкие веточки и листья с плеч, поприветствовал Пирожок одного из этой шайки. - Почему-то я не удивлён, увидев тебя здесь. И когда это ты успел стать тимлидом, а?
- Ойц. - произнёс подельник Хосе.
- Здравствуйте, сэр! - произнёс другой.
- Что, Хосе, может, снова декану пожалуешься?
Хосе стоял как оплёваный. Пирожок согласно кивнул, как будто именно такого ответа он и ожидал, и коротко распорядился:
- Извинись перед дамой!
- Простите, мэм! Я ничего такого не имел в виду. - повернулся ко мне Хосе.
Я благосклонно кивнула и взяла под руку Пирожка. В другой руке у него был тяжёлый пакет с инжиром:)))
- Как я и сказала, там дальше есть и другие деревья. - Я махнула рукой в сторону. И мы с Пирожком чинно покинули инжирные кущи и прифигевших латинос.
- Блядь, как же я вляпался! - закрыл глаза рукой Пирлжок.
- Не ссы, любовь моя! Главное - апломб! Никто и никуда жаловаться не пойдёт. Мы ж с этими мексиканцами теперь подельники. - Успокоила я Пирожка.
Но это было зря. Хосе на следующее утро рысью метнулся к дину и настучал ему на Пирожка. После чего Пирожок снова был приглашён на кофе с коньяком, а мексиканец был сослан в другое здание.
Но какая гнида, а?! А ведь я ему ещё деревья другие указала! Знала бы, так ни в жисть! Гнида, она гнида и есть.